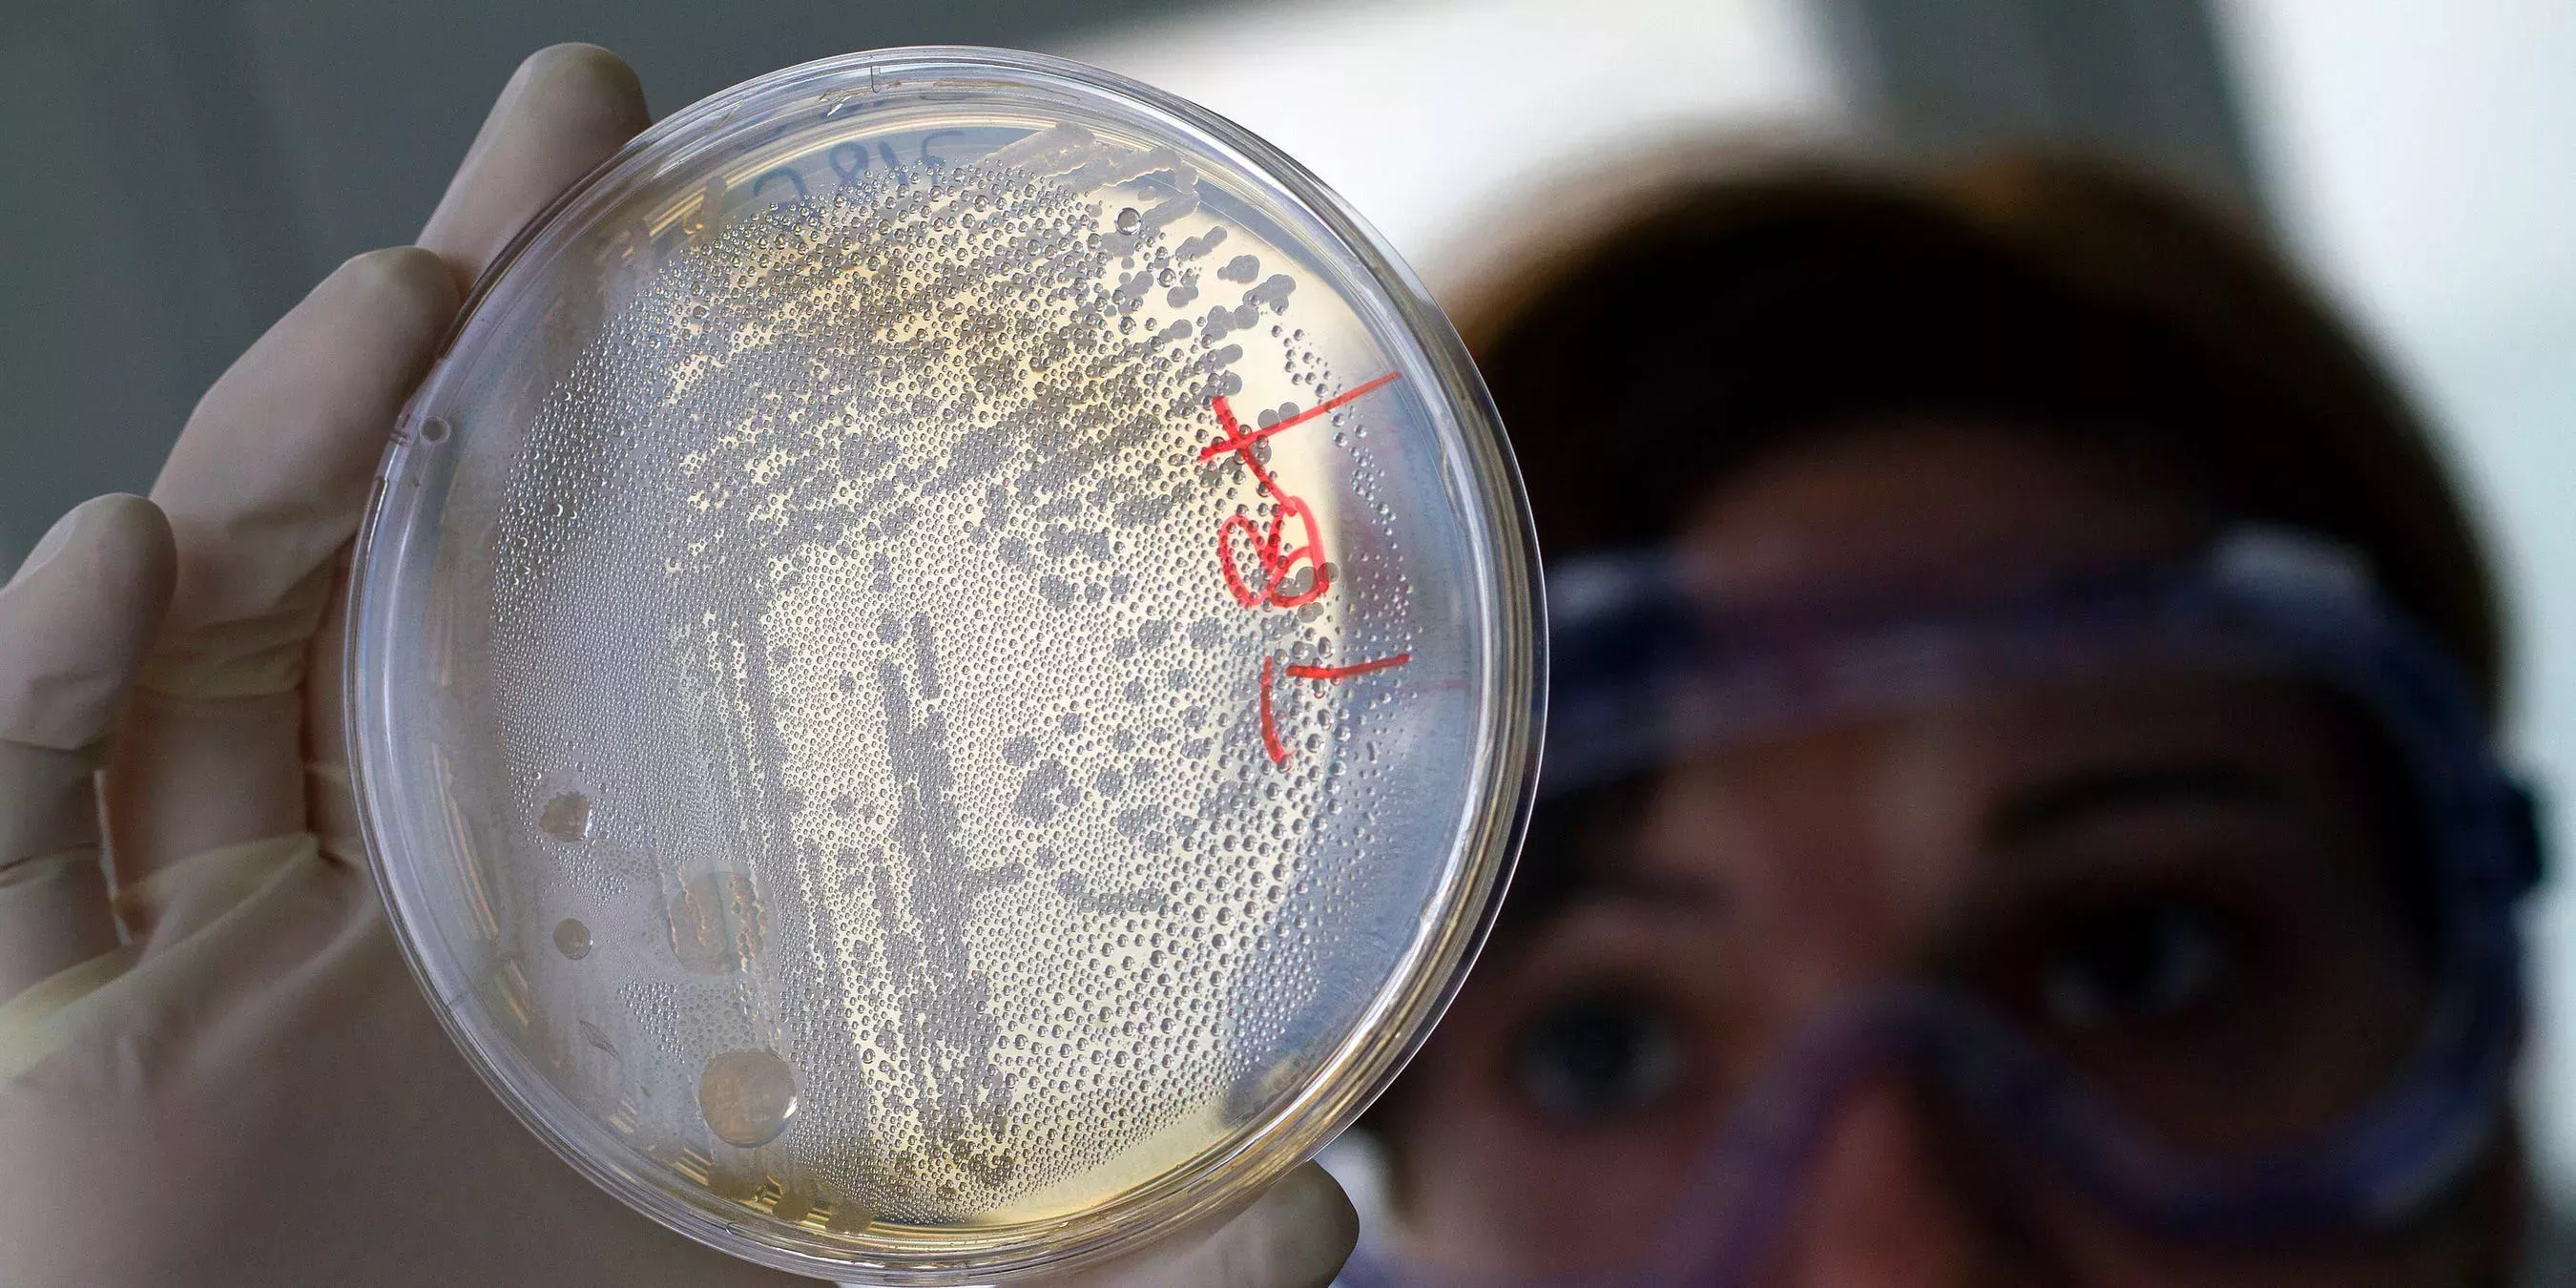
Los CDC relacionan el misterioso brote de E. coli con los sándwiches de Wendy's con lechuga romana

Los CDC relacionan el misterioso brote de E. coli con los sándwiches de Wendy's con lechuga romana
Muchas de las personas enfermas de E. coli en Ohio, Michigan y Pennsylvania declararon haber comido en restaurantes Wendy's una semana antes de enfermar, según informaron el viernes los Centros para el Control y la Prevención de Enfermedades.
Los CDC han contabilizado un total de 37 enfermos infectados por la cepa de E. coli del brote hasta el viernes por la tarde. La agencia anunció inicialmente el brote el miércoles, y desde entonces ha actualizado el recuento de casos y los estados afectados.
Aunque las autoridades sanitarias aún no han confirmado que un alimento o restaurante específico sea la fuente de este brote, las pruebas apuntan a la lechuga romana que se sirve sobre las hamburguesas y los sándwiches de Wendy's. En aras de la precaución, la cadena de comida rápida está retirando la lechuga de los sándwiches en los locales de la región afectada, informaron los CDC. Wendy's utiliza un tipo diferente de lechuga romana en las ensaladas.
Los CDC relacionan el brote de listeria en varios estados con un fabricante de helados de Florida ¿Cuántas calorías tiene 100 gramos de lechuga romana?
De los 26 pacientes que hablaron con los CDC, 22 de ellos declararon haber comido en un restaurante Wendy's en la semana anterior al inicio de su enfermedad. Muchos de ellos pidieron hamburguesas o sándwiches, por lo que la lechuga incluida en ambas comidas fue uno de los ingredientes más comunes consumidos por los enfermos.
Al menos 10 personas han sido hospitalizadas con síntomas como calambres estomacales severos, diarrea y vómitos debido a la E. coli desde que el brote comenzó el 26 de julio. Sin embargo, no todas las personas que experimentan estos síntomas de E. coli buscan atención médica, y muchos casos potencialmente relacionados siguen siendo investigados.
Según Marler Clark, un bufete de abogados que representa a algunas de las personas enfermas en Ohio, los departamentos de salud estatales y locales han notificado un total de 116 casos de E. coli -18 casos en Ohio y 98 casos en Michigan- durante las dos primeras semanas de agosto.
Los CDC han confirmado que 19 casos en Ohio, 15 en Michigan, dos en Pensilvania y uno en Indiana están relacionados con el brote.
Las verduras de hoja verde, como las espinacas y la lechuga romana, son portadoras habituales de E. coli porque se cultivan al aire libre y a menudo se consumen crudas, dijo Marler. La cocción de los alimentos ayuda a eliminar los gérmenes que pueden enfermar, por lo que los productos frescos son más propensos a causar un brote hoy en día en comparación con algo como la carne de hamburguesa.
"No es por manchar las verduras de hoja verde, pero ese sería el culpable más probable", dijo Marler. "Dado el corto plazo de estas enfermedades, lo más probable es que sea un artículo perecedero".
Si la culpa fuera de un alimento con una vida útil más larga, la gente habría enfermado durante un periodo de tiempo más largo, añadió. Las verduras frescas sólo duran una o dos semanas antes de estropearse, lo que coincidiría con el hecho de que las personas consumieran alimentos contaminados y enfermaran entre el 26 de julio y el 6 de agosto.
Además, la cepa E. coli O157:H7 ha sido identificada en casos recientes, así como en brotes anteriores relacionados con verduras de hoja verde. En agosto y septiembre de 2006, un total de 199 personas enfermaron y 3 murieron debido a la infección por esa misma cepa, que posteriormente se relacionó con las espinacas crudas.
Los CDC informaron de dos brotes menores de E. coli relacionados con la cepa O157:H7 en 2021. Uno estaba relacionado con las espinacas tiernas, mientras que el otro se remontaba a las ensaladas envasadas.
La investigación está en curso
Es probable que el número real de casos de E. coli relacionados con el brote sea mayor que el número notificado, ya que se tarda entre 3 y 4 semanas en determinar si una persona enferma forma parte de un brote, dijeron los CDC en un aviso de investigación. Los casos señalados han afectado a personas de todas las edades, desde los 6 hasta los 91 años.
"Aunque los informes de enfermedades por E. coli suelen aumentar durante los meses más cálidos del verano, este salto significativo en los casos es alarmante", dijo el martes en un comunicado de prensa la Dra. Natasha Bagdasarian, jefa médica del Departamento de Salud y Servicios Humanos de Michigan.
Los CDC no aconsejan que la gente evite comer en los restaurantes Wendy's ni que deje de comer lechuga romana en este momento.
Para evitar enfermar de E. coli, las autoridades sanitarias recomiendan enjuagar las frutas y verduras frescas antes de comerlas o prepararlas, y lavarse las manos y los utensilios con agua y jabón para eliminar los gérmenes antes y después de cocinar. Asegúrese de separar la carne y los huevos crudos de los alimentos listos para consumir, y cocine los alimentos crudos a la temperatura correcta para reducir el riesgo de contraer enfermedades transmitidas por los alimentos.
